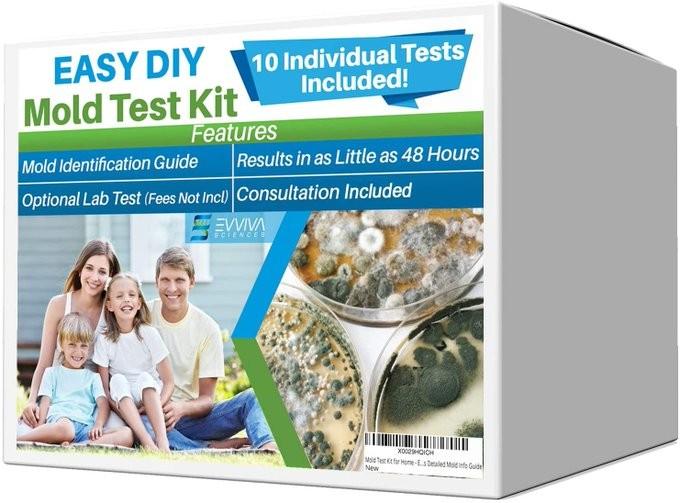

About us The Mold Facts is a leading information portal with a unique selection of guides, resources, and articles about mold and allergies. From learning about mold and allergies to the latest HEPA filters and Air purifiers to choosing the right DIY mold testing kits, you can find exclusive moldrelated information online here.

Mold Inspection Santa Clarita Looking for professionals for mold inspection Santa Clarita? Contact mold inspection experts at 8666747541 or visit Themoldfacts.com to know more.


How Much Does Mold Removal Cost? How much does mold removal cost? Typical costs may vary between $800 and $2500. However, you should consult mold experts on 8666747541 for the best quotes. Visit Themoldfacts.com.

Air Purifiers For Allergies Installing one of the best air purifiers for allergies is now easy if you visit Themoldfacts.com to know the right facts about brands and their services.


Best Air Purifier For Mold Want to buy the best air purifier for mold and allergies? Visit Themoldfacts.com to know more about mold facts, inspection, testing, and removal.


Contact us 5318 Canoga Ave. Unit A, Woodland Hills, CA, 91364 USA 8666747541

Thank you
